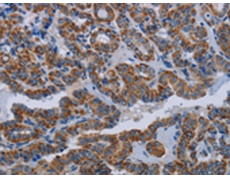
一抗

中文名稱: 兔抗NDUFS8多克隆抗體
英文名稱: Anti-NDUFS8 rabbit polyclonal antibody
別 名: TYKY; CI-23k; CI23KD
相關(guān)類別: 一抗
儲 存: 冷凍(-20℃)
宿 主: Rabbit
抗 原: NDUFS8
反應(yīng)種屬: Human, Mouse
標(biāo) 記 物: Unconjugate
克隆類型:rabbit polyclonal
技術(shù)規(guī)格
|
Background: |
This gene encodes a subunit of mitochondrial NADH:ubiquinone oxidoreductase, or Complex I, a multimeric enzyme of the respiratory chain responsible for NADH oxidation, ubiquinone reduction, and the ejection of protons from mitochondria. The encoded protein is involved in the binding of two of the six to eight iron-sulfur clusters of Complex I and, as such, is required in the electron transfer process. Mutations in this gene have been associated with Leigh syndrome. |
|
Applications: |
ELISA, WB, IHC |
|
Name of antibody: |
NDUFS8 |
|
Immunogen: |
Fusion protein of human NDUFS8 |
|
Full name: |
NADH dehydrogenase (ubiquinone) Fe-S protein 8, 23kDa |
|
Synonyms: |
TYKY; CI-23k; CI23KD |
|
SwissProt: |
O00217 |
|
ELISA Recommended dilution: |
2000-5000 |
|
IHC positive control: |
Human thyroid cancer and human brain |
|
IHC Recommend dilution: |
25-100 |
|
WB Predicted band size: |
24 kDa |
|
WB Positive control: |
Jurkat cells, mouse heart and brain tissue |
|
WB Recommended dilution: |
500-2000 |


 購物車
購物車 幫助
幫助
 021-54845833/15800441009
021-54845833/15800441009